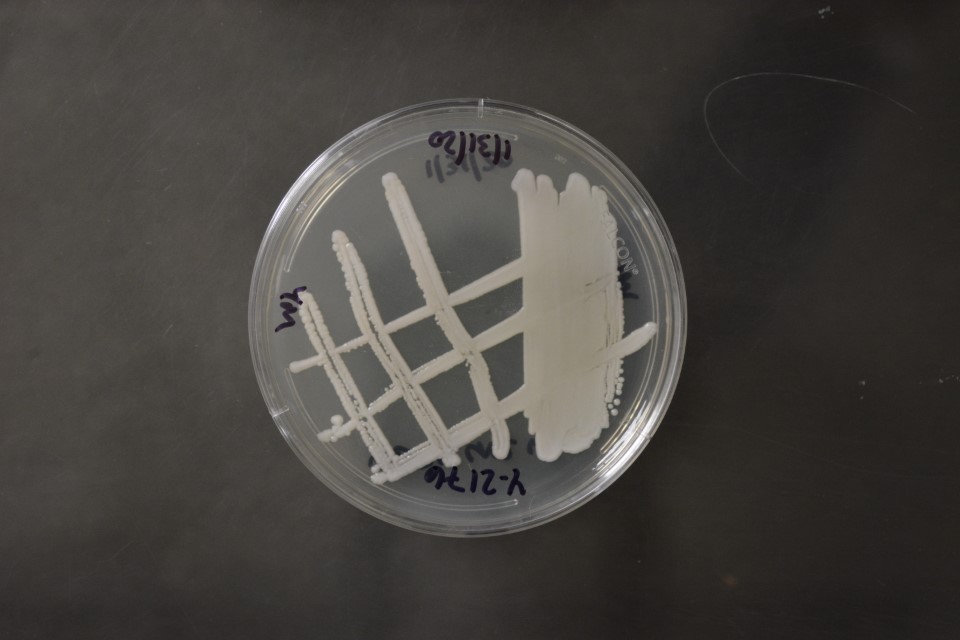

Nakaseomyces delphensis
NRRL Y-2379(Type Strain)
Accession numbers in other collections:ATCC 24205=CBS 2170=DBVPG 6073=IFO 10602=NCYC 768=UCD-FST 56-2=VKM Y-1529
Source:CBS
Isolated from(substrate):FRT,dried figs,sugar
Substrate location:Western Cape Province,South Africa
Genetic info:Robnett PCR#662,GB U69576.GenBank:LSU(AY046097),SSU(X83823),ITS(AY046166),EF-1 alpha(AF402030),mito SSU(AF442300).
Growth media:Yeast Extract-Malt Extract-Peptone-Glucose(YM for yeasts)(number 6)
Optimum growth temperature:25C
Strain images:
NRRL_Y-2379_6.JPG